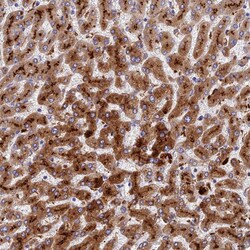

Promotional price valid on web orders only. Your contract pricing may differ. Interested in signing up for a dedicated account number?
Learn More
Learn More
Invitrogen™ ADAMTS13 Polyclonal Antibody


Rabbit Polyclonal Antibody
Supplier: Invitrogen™ PA5111145
Description
Immunogen sequence: AHQEDTERYV LTNLNIGAEL LRDPSLGAQF RVHLVKMVIL TEPEGAPNIT ANLTSSLLSV CGWSQTINPE DDTDPGHADL VLYITRFDLE LPDGNRQV.
ADAMTS13 is a member of the ADAMTS (a disintegrin and metalloproteinase with thrombospondin motif) protein family. Members of the family share several distinct protein modules, including a propeptide region, a metalloproteinase domain, a disintegrin-like domain, and a thrombospondin type 1 (TS) motif. Individual members of this family differ in the number of C-terminal TS motifs, and some have unique C-terminal domains. The enzyme is the von Willebrand Factor (vWF)-cleaving protease, which is responsible for cleaving at the site of Tyr842-Met843 of the vWF molecule. A deficiency of this enzyme is associated with thrombotic thrombocytopenic purpura.
Specifications
| ADAMTS13 | |
| Polyclonal | |
| Unconjugated | |
| ADAMTS13 | |
| a disintegrin and metalloproteinase; A disintegrin and metalloproteinase with thrombospondin motifs 13; A disintegrin and metalloproteinase with thrombospondin motifs 13-like; a disintegrin-like and metallopeptidase (reprolysin type) with thrombospondin type 1 motif, 13; a disintegrin-like and metalloprotease (reprolysin type) with thrombospondin type 1 motif, 13; ADAM; ADAM metallopeptidase with thrombospondin type 1 motif 13; ADAM metallopeptidase with thrombospondin type 1 motif, 13; ADAMs; ADAM-TS 13; ADAMTS13; ADAM-TS13; ADAMTS-13; C9orf8; Gm710; LOC102554393; metalloendopeptidases; UNQ6102/PRO20085; von Willebrand factor-cleaving protease; vWF-cleaving protease; VWFCP; vWF-CP; vWF-CP mRNA for von Willebrand factor-cleaving | |
| Rabbit | |
| Antigen Affinity Chromatography | |
| RUO | |
| 11093 | |
| Store at 4°C short term. For long term storage, store at -20°C, avoiding freeze/thaw cycles. | |
| Liquid |
| Immunohistochemistry (Paraffin) | |
| 0.2 mg/mL | |
| PBS with 40% glycerol and 0.02% sodium azide; pH 7.2 | |
| Q76LX8 | |
| ADAMTS13 | |
| Recombinant Protein corresonding to Human ADAMTS13. Recombinant protein control fragment (Product #RP-98516). | |
| 100 μL | |
| Primary | |
| Human | |
| Antibody | |
| IgG |
Product Content Correction
Your input is important to us. Please complete this form to provide feedback related to the content on this product.
Product Title
Spot an opportunity for improvement?Share a Content Correction